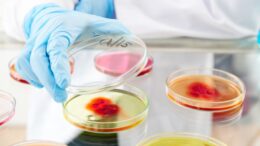

Understanding Modern Infectious Diseases and Their Impacts
Curbing or even containing a pandemic breakout like COVID-19 almost always implies unpalatable choices between lost lives and livelihoods. The authors of a new study just published in the Journal…